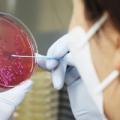

지난 뉴스
속초 호텔 식중독 의심 증상자 총 6명…시, 역학조사 본격화
없습니다.) 강원 속초 한 호텔에서 투숙객들이 식중독 의심 증세를 보여 보건당국이 본격적인 역학조사에 나섰습니다. 오늘(17일) 속초시 보건당국에... 식중독 증세를 보인 6명과 호텔 식당 등에서 바이러스는 검출되지 않았으며, 증상자들은 모두 응급 치료를 받고 귀가했습니다. 검사 결과는 이달 말 나올...
SBS | 기사작성일 : 2025-11-17

속초 호텔 식중독 의심 증상자 총 6명…시, 역학조사 본격화
조사 강원 속초 한 호텔에서 투숙객들이 식중독 의심 증세를 보여 보건당국이 본격적인 역학조사에 나섰다. 17일 속초시 보건당국에 따르면 전날 대포동... 식중독 증세를 보인 6명과 호텔 식당 등에서 바이러스는 검출되지 않았으며, 증상자들은 모두 응급 치료받고 귀가했다. 식중독은 크게 바이러스성과...
연합뉴스 | 기사작성일 : 2025-11-17

[기후위기 변화의 기로] 기후위기가 바꾼 우리의 일상
온열질환으로 치료를 받 은 군인은 2020년 846명, 2021년 1천28명, 2022년 1천109명 순으로 증가했다. "하늘을 이길 수 없었습니다"…계절 축제 열기도 고민... 강원 속초시는 올해 최초로 과거 3년 치 기후 데이터를 추출해 벚꽃 축제를 준비했 다. 데이터상으로 3월 말이 가장 적절한 축 제 시기라는 결과가 나와 3월...
당진시대 | 기사작성일 : 2025-11-17

속초 한 호텔서 투숙객 잇따라 구토·설사 등 식중독 의심 증상 호소
강원 속초시의 한 호텔 투숙객들이 복통과 구토 등 식중독 의심 증세를 보여 보건 당국이 역학조사에 나섰다. 지난 15일 오후 10시 27분쯤 속초지역의 한 호텔 투숙객 A씨(45)와 B씨(45)가 복통, 구토 등의 증세를 보여 인근 병원에서 치료를 받았다. 또 이날 오후 10시 52분~11시 36분 사이 다른 투숙객 2명도 같은...
경향신문 | 기사작성일 : 2025-11-16

[속보] 속초 호텔서 식사 투숙객들 식중독...병원서 치료
강원도 속초시의 한 호텔에서 투숙객들이 뷔페를 이용했다가 잇따라 식중독 증세를 보였다. 16일 연합뉴스에 따르면 전날 오후 10시27분께 속초시 대포동의 한 4성급 호텔에서 투숙객인 40대 A씨와 B씨가 복통, 구토 등에 시달리다 인근 병원에 옮겨졌다. 이후 한시간이 채 지나기도 전에 60대 투숙객과 40대...
경기일보 | 기사작성일 : 2025-11-16

속초 호텔 뷔페 먹고 설사·구토…‘식중독 의심’ 보건 당국 역학조사
강원 속초시의 한 호텔 투숙객들이 복통과 구토 등 식중독 의심 증세를 보여 보건 당국이 역학조사에 나섰다. 지난 15일 오후 10시 27분쯤 속초지역의 한 호텔 투숙객 A씨(45)와 B씨(45)가 복통, 구토 등의 증세를 보여 인근 병원에서 치료를 받았다. 또 이날 오후 10시 52분~11시 36분 사이 다른 투숙객 2명도 같은...
디지털타임스 | 기사작성일 : 2025-11-16

국힘 의원이 본회의서 소개한 글 보니..."반국가 세력이 대통령 체포, 유...
더불어민주당은 병역 면제 과정 파악을 위한 의료 진료 기록과 아들의 임대보증금 증여 의혹에 관한 보증금 계약서 및 지명 직전까지 행정사로 일하며... 이양수(강원 속초시인제군고성군양양군), 이인선(대구 수성구을), 이종배(충북 충주시), 이종욱(경남 창원시진해구), 이철규(강원...
오마이뉴스 | 기사작성일 : 2025-11-16

[속초소식] 지역사랑상품권 우수 실적 보답…캐시백 혜택 확대
▲ 지역사랑상품권 우수 실적 보답…캐시백 혜택 확대 = 강원 속초시는 지역사랑상품권 판매실적 우수 지자체로 선정돼 국비 2억7천만원을 받았다고 10일... 점검 대상은 국민건강증진법에 따른 어린이집, 유치원, 학교, 의료기관, 사회복지시설 등 흡연 취약 시설과 속초시 조례에 지정된 도시공원, 버스·택시...
연합뉴스 | 기사작성일 : 2025-11-10

설악산 금강굴 인근서 60대 등산객 추락…헬기로 병원 이송
9일 오후 1시 28분쯤 강원 속초시 설악동 설악산 금강굴 인근에서 A 씨(66)가 하산 중 약 30m 아래로 떨어지는 사고가 발생했다. 이 사고로 A 씨는 머리 등 부위에 큰 부상을 입어 소방 헬기에 의해 경기 의정부 대형 병원으로 이송돼 치료받고 있다. 당국은 사고 경위를 조사하고 있다.
뉴스1 | 기사작성일 : 2025-11-09

‘통합돌봄’ 시행 다섯 달 앞으로…과제 여전
재가 의료에 필수적인 역할을 하는 '장기요양 재택의료센터'도 강원도 내 6개 시군, 8곳 지정에 불과합니다. 특히 영동지역은 강릉의료원 단 한 곳뿐입니다. 각 시군은 의원 등 의료기관을 대상으로 참여 독려와 홍보를 강화하고 있습니다. [신정현/속초시 통합돌봄TF팀장 : "(현재까지) 한의원 5개소, 의원...
KBS | 기사작성일 : 2025-11-07

‘통합돌봄’ 시행 다섯 달 앞으로…과제 여전
재가 의료에 필수적인 역할을 하는 '장기요양 재택의료센터'도 강원도 내 6개 시군, 8곳 지정에 불과합니다. 특히 영동지역은 강릉의료원 단 한 곳뿐입니다. 각 시군은 의원 등 의료기관을 대상으로 참여 독려와 홍보를 강화하고 있습니다. [신정현/속초시 통합돌봄TF팀장 : "(현재까지) 한의원 5개소, 의원...
KBS | 기사작성일 : 2025-11-06

강원 고성소방서-속초소방서, 2025년 긴급구조종합훈련 전개
이번 훈련은 숙박시설 및 도심형 산림화재 복합재난 대응훈련으로 진행됐으며 속초시와 고성군 내 23개 유관기관에서 장비 72대, 인원 362명이 참여했다. 이날 훈련은 △초기 화재대응 및 인명구조 △리조트 내 화재 진압 △대피 유도 및 응급의료지원 △산불 확산 저지 등 단계별 대응체계에 중점을 두고...
쿠키뉴스 | 기사작성일 : 2025-11-06

‘통합돌봄’ 시행 다섯 달 앞으로…과제 여전
재가 의료에 필수적인 역할을 하는 '장기요양 재택의료센터'도 강원도 내 6개 시군, 8곳 지정에 불과합니다. 특히 영동지역은 강릉의료원 단 한 곳뿐입니다. 각 시군은 의원 등 의료기관을 대상으로 참여 독려와 홍보를 강화하고 있습니다. [신정현/속초시 통합돌봄TF팀장 : "(현재까지) 한의원 5개소, 의원...
KBS | 기사작성일 : 2025-11-06

‘통합돌봄’ 시행 다섯 달 앞으로…과제 여전
재가 의료에 필수적인 역할을 하는 '장기요양 재택의료센터'도 강원도 내 6개 시군, 8곳 지정에 불과합니다. 특히 영동지역은 강릉의료원 단 한 곳뿐입니다. 각 시군은 의원 등 의료기관을 대상으로 참여 독려와 홍보를 강화하고 있습니다. [신정현/속초시 통합돌봄TF팀장 : "(현재까지) 한의원 5개소, 의원...
KBS | 기사작성일 : 2025-11-06

속초시, 복지급여 1482건 대상 확인조사 추진
소득·재산 변동 점검으로 복지 사각지대 예방 강원 속초시(시장 이병선)가 2025년 하반기 사회보장급여 확인조사를 12월 31일까지 실시한다. 이번 조사는... 시는 보건복지부, 국세청, 건강보험공단, 금융기관 등 관계기관의 정보를 연계해 소득과 재산 변동사항을 종합적으로 확인할 계획이다. 조사 결과 변동이...
NSP통신 | 기사작성일 : 2025-11-04

민주당 속초인제고성양양 "속초의료원 임금체불, 지자체가 적극 나서야"
한눈에 보는 오늘 : 사회 - 뉴스 : 더불어민주당 속초인제고성양양 지역위원회가 속초의료원 임금체불과 관련해 강원도와 속초시의 적극적인 대응을 촉구하고 나섰다.
네이트뉴스 | 기사작성일 : 2025-11-04

민주당 ‘속인고양’ “속초의료원 재정난 해소해야”
지역위는 오늘(3일) 입장문을 내고 속초의료원 적자 누적과 임금 체불이 의료 인력 이탈로 이어져 공공 의료시스템이 무너지고 있다며, 강원도와 강원도의회, 속초시가 책임 의식을 갖고 대책을 마련해야 한다고 주장했습니다. 지역위는 보건복지부와 고용노동부에 강원도 내 5개 공공 의료원에 대한 체불임금...
KBS | 기사작성일 : 2025-11-03

민주당 "속초의료원 임금체불 20억…공공의료 붕괴 위기"
위원회는 "예산편성과 지도·감독 권한을 가진 김진태 도지사는 아무런 책임의식 없이 사태를 방치하고 있다"며 "속초시 역시 강원도에 어떠한 항의나 대책 요구도 하지 않고 있다"고 주장했다. 이들은 "김진태 도지사는 예산권과 감독권을 행사해 속초의료원의 재정난과 임금체불 사태를 즉각 해소하라"고...
뉴스1 | 기사작성일 : 2025-11-03

민주당 속초지역위 "속초의료원 임금체불…지자체 적극 나서야"
20억원 달하는 직원 급여 미지급…"지역거점 공공 의료 붕괴 초래" 더불어민주당 속초인제고성양양 지역위원회가 속초의료원 임금 체불 해결을 위해 강원특별자치도와 속초시의 적극적인 대응을 촉구했다. 지역위는 3일 입장문을 통해 "속초의료원은 적자 누적에 차입금으로 버티고 있고 임금체불이 장기화하고...
연합뉴스 | 기사작성일 : 2025-11-03

[2일 오늘의 사건사고]경기 포천시 영중면 성동리 양돈농장서 화재 등
밭, 강원 속초시 교동의 한 아파트 2층 등에서 화재· 사고 등이 발생했다. ▲경기소방재난본부 로고 (사진=경기소방재난본부 제공) ◆경기 포천시... 이 불로 주택에 거주하던 60대 남성 2명이 심정지 상태로 병원에 이송됐으나, 1명이 치료 중 사망했다. 소방 당국은 장비 18대와 인력 56명을 동원해 43분만에...
매일안전신문 | 기사작성일 : 2025-11-03
상기 뉴스 정보는 지능형 빅데이터분석에 의해 약 99%의 정확도로 제공됩니다.
 5.0℃
5.0℃
